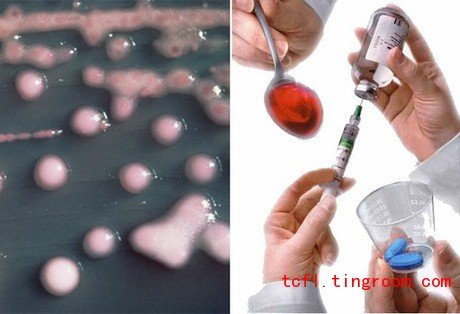
Extensive Reading Lesson 37

路透社报道,一种产生于印度的超级细菌很可能会伴着医疗旅游在全世界蔓延开来,目前几乎没有药物可以对付它。科学家是在南亚和英国的一些病人身上发现这种叫做NDM-1的新型基因的。它所产生的细菌对包括碳青霉烯类抗生素在内的几乎所有抗生素都具有抗药性,而碳青霉烯类抗生素是紧急治疗抗药性病症的终极手段。研究发现,大多数NDM-1超级细菌出现在大肠杆菌以及可以自由复制和变异的DNA结构中。在确认的患者中,印度钦奈市有44人,印度哈里亚纳邦26人,英国37人,孟加拉国、巴基斯坦和印度其它地方共73人。研究人员透露,部分英国患者最近曾前往印度或巴基斯坦接受治疗,有的做了整形手术。
泥石流遇难人数升至1117
据新华社报道,在甘肃省舟曲县发生的特大泥石流灾害中,死亡人数已上升至1117人,627人仍然下落不明。567位幸存人员已接受医疗,另外64位重伤者仍住院接受治疗。周三晚,舟曲县遭受了暴风雨袭击,致使另外三人失踪,更使寻找到更多生还者的希望渺茫。据预报,大雨可持续到周五,这可能会引发白龙江上的堰塞湖决口,淹没本已遭到重创的灾区。另外一次泥石流阻塞了两河口到舟曲的公路,此公路是从省会兰州到舟曲最近的救灾物资输送道路。迄今为止,舟曲还未有爆发传染病或公共卫生事件的报告。
有影响力囚犯 黄光裕居首
美国《外交政策》杂志8月10日盘点了世界上最有影响力的五大囚犯。其中,前中国首富﹑国美电器前主席黄光裕位列首位,之后依次是俄罗斯前首富米哈伊尔·霍多尔科夫斯基、第一次世贸大厦袭击策划者奥马尔·阿卜杜勒·拉曼、法塔赫领导人马尔万·巴尔古提和缅甸反对党领导人昂山素季。
中国基督教徒占总人口1.8%
中国社科院在周三发布的《宗教蓝皮书》中估算,中国现有基督徒2300万人,约占全国人口总数的1.8%。其中,因疾病而信仰基督教的信徒占到了近70%。报告显示,近年来,中国基督教徒群体规模增长较快,1993年以来开始信教的基督徒占信徒总数的73%。中国基督徒以女性居多,大概占到了七成。若从受教育程度来看,中国基督徒受教育程度普遍偏低,大专及以上学历者仅占2.6%。
银监会首次全面规范信用卡
《东方早报》消息,中国银监会周三下发了《商业银行信用卡业务监督管理办法》,进一步完善了1996年下发的《信用卡业务管理办法》。新办法旨在全面规范中国的信用卡市场。截至目前,商业银行信用卡发行总量已达1.85亿张。银监会还特别强调不得向未激活卡收费,不得向未成年人发放信用卡。
贝克汉姆国家队生涯终结
据美国有线电视新闻网报道,英格兰国家队主帅卡佩罗宣布将不征召贝克汉姆参加即将举行的2012欧洲杯预选赛,这标志着前队长、现年35岁的贝克汉姆的国家队生涯就此终结。贝克汉姆的发言人坚持声称小贝从未做出任何从国家队退役的决定。
拉登大厨被判14年
据路透社报道,美国一军事法庭于周三判处奥萨马·本拉登的前厨师易卜拉欣·阿尔库西14年有期徒刑,但是在秘密抗辩交易之下,他的服刑期应该会短得多。来自苏丹现年50 岁的库西上个月在关塔那摩湾的特别法庭认罪,罪行为与基地组织合伙策划阴谋,并为恐怖活动提供物质支持。他被囚禁在关塔那摩已逾8年。库西是奥巴马政府下第一个被判处有罪的关塔那摩囚犯。
“苹果皮”是否侵权为投资者顾虑
新加坡《联合早报》报道称,中国一款发明能将苹果iPod touch转变为iPhone,吸引了投资者的兴趣。这款名为“苹果皮520”的产品包含一块电池、天线、麦克风、接收器和SIM卡插槽,能让iPod touch拥有所有iPhone的功能。不过潜在投资者们很可能会对该产品的法律因素心存顾虑,因为此项发明触及了苹果公司的商业利益。不过一些业内人士相信这款产品能够帮助下拉iPhone价格。
申雪赵宏博婚礼需门票
据《北京晨报》报道,中国花样滑冰伉俪申雪、赵宏博的婚礼将以冰上表演的形式于9月4日在首都体育馆举行,届时婚礼最贵门票高达1080 元。但是赵宏博否认这样做是为了钱。据传,受邀的嘉宾包括俄罗斯的叶甫根尼·普鲁申科和阿列克谢·康斯坦丁诺维奇·亚古丁、日本的浅田真央、瑞典的斯蒂凡·兰比尔、美国的约翰尼·G·威尔等花样滑冰名将。
希尔顿误戴假发被诉
据美联社报道,一家制造毛发延长产品的公司——国际毛发科技公司——周三将29岁的社交名媛帕丽斯·希尔顿告上法庭。此公司声称希尔顿没有按照合同推广他们的产品。希尔顿曾于2008年戴着他们竞争对手的假发,在公众场合露面。此公司寻求3500万美元的损失赔偿,并表示希尔顿纸醉金迷的生活方式也与公司的市场推销战略不符。诉状中还提到希尔顿没有参加公司于2007年为其毛发延长系列产品举行的启动酒会。彼时,她正坐牢。
焦虑妇女难怀孕
据英国广播公司报道,最新一项科学研究首次发现,心理压力会降低女性怀孕的几率,这一成果被刊登在美国《生育与不孕》杂志上。该研究测试了274名年龄在18至40岁之间、期盼能自然怀孕的妇女。结果发现,在最容易怀孕的日子里(排卵期),α淀粉酶水平(肾上腺素水平的标志)最高的妇女比α淀粉酶水平最低的妇女成功怀孕几率降低了12%。专家建议,为了能健康顺利地怀孕,孕前女性应该设法放松身心。放松训练、专家咨询、练习瑜珈和沉思冥想都是不错的选择。
New superbug spreading from India
A new superbug from India could spread around the world — in part because of medical tourism — and scientists said few drugs are available to treat it, Reuters reported. The new gene called New Delhi metallo-beta-lactamase (NDM-1) was found in patients in South Asia and in Britain. NDM-1-producing bacteria are resistant to almost all antibiotics including carbapenems, a class of drugs reserved for emergency use and to treat infections caused by other multi-resistant bugs. It has been largely found in E. coli bacteria and on DNA structures that can be easily copied and passed onto other types of bacteria. Researchers have found 44 NDM-1-positive bacteria in Chennai, 26 in Haryana, 37 in Britain, and 73 in other sites in Bangladesh, India and Pakistan. Several of the British NDM-1 positive patients had traveled recently to India or Pakistan for hospital treatment, including cosmetic surgery, they said.
Mudslide death toll rises to 1,117
The death toll from the massive mudslides in Zhouqu County, Gansu Province has risen to 1,117, with 627 still missing, Xinhua reported. A total of 567 survivors have been treated and a further 64 seriously injured people have been hospitalized. Hopes of finding any more survivors faded as thunderstorms battered the county Wednesday night, leaving another three people missing. Heavy rains forecast through Friday could cause a barrier lake formed on the Bailong River to burst and flood already-devastated areas. Another mudslide has blocked the Lianghekou-Zhouqu Road, which is the shortest route for bringing relief goods from the provincial capital Lanzhou. So far there have been no reports of epidemic outbreaks or major public health incidents.
World’s most powerful prisoners
The August 10 issue of the Foreign Policy magazine listed the five most powerful people behind bars. Huang Guangyu, Gome’s former chairman and the richest man in China ranks first. Mikhail Khodorkovsky, once the richest man in Russia, finished second. Third is Omar Abdel-Rahman, the mastermind of the first World Trade Center bombing. Marwan Barghouti, the leader of the Palestinian Fatah movement, and Burmese opposition leader Aung San Suu Kyi come fourth and fifth, respectively.
1.8% of population is Christian
China has about 23 million Christians, accounting for 1.8 percent of the total population, according to the Religion Blue Book published by the Chinese Academy of Social Sciences on Wednesday. Nearly 70 percent of Christians joined the faith after experiencing health problems. The report also shows Christian communities in China have grown rapidly in recent years: 73 percent of the believers converted since 1993. Of the Christians, women make up 70 percent of the faith group. A relatively low education level is common among Chinese Christians; only 2.6 percent went to college.
Regulator standardizes credit cards
The Oriental Morning Post reported that the China Banking Regulatory Commission Wednesday issued new regulatory measures on credit cards, an amendment to an earlier one issued in 1996. The new measures intend to standardize China’s credit card market where a total of 185 million credit cards have been issued by commercial banks. The CBRC also specifically forbids charging fees to inactive cards and issuing cards to minors.
Beckham’s England career over
David Beckham’s international career has ended after England coach Fabio Capello announced he wouldn’t enlist the 35-year-old former captain to play for the upcoming Euro 2012 qualifiers. Beckham’s spokesman insisted the player had not made a decision to end his England career, CNN reported.
Bin Laden’s cook gets 14 years
A US military tribunal Wednesday sentenced Osama bin Laden’s former cook Ibrahim al Qosi to 14 years in prison, but he is expected to serve far less under the terms of an undisclosed plea bargain, Reuters reported. 50-year-old Qosi, who is from Sudan, pleaded guilty last month in a special court in Guantanamo Bay, to charges of conspiring with al Qaeda and providing material support for terrorism. Qosi has been held at Guantanamo for more than 8 years. He was the first Guantanamo captive to be convicted under the administration of President Barack Obama.
Legal snags hit iPod extension
A Chinese invention to turn an iPod touch into an iPhone has attracted investor interest, according to Zaobao.com. The product, Apply Skin 520, includes a battery, an aerial, a microphone, a receiver and a SIM card slot, and gives an iPod touch all the features of an iPhone. Potential investors are likely to be concerned about legal issues surrounding the device, as it affects Apple’s commercial interests. But some insiders think the device may help bring down the price of iPhones.
Skating pair’s ticket-only wedding
Chinese figure skating couple, Shen Xue and Zhao Hongbo are to hold their wedding in the form of a skating performance at the Capital Gymnasium on Sept. 4. Tickets will cost up to 1,080 yuan (US$160), according to the Beijing Morning Post. But Zhao Hongbo denied the couple is out to make money. The guest list is rumored to include skating stars Evgeni Plushenko and Alexei Yagudin from Russia, Asada Mao from Japan, Stephane Lambiel from Sweden, and Johnny G. Weir from the U.S.
Paris Hilton sued for wearing wrong hair
Hair extension company Hairtech International is suing 29-year-old socialite Paris Hilton for breaching a contract to promote their products by sporting the fake locks of a competitor back in 2008, AP reported. The company is seeking US$35 million indamages and also cites Hilton’s partying as damaging its marketing campaigns. The company also claims Hilton missed a launch party for a hair extension line in 2007. She was in jail at the time.
High stress ‘delays pregnancy’
For the first time, a scientific study has shown that high stress levels may delay pregnancy, the BBC reported. The study, published in the journal Fertility and Sterility, measured 274 healthy women aged 18-40 planning a baby naturally. Women with the highest levels of alpha-amylase (an indicator of adrenalin levels) had about a 12 percent reduced chance of getting pregnant during their fertile days compared with those with the lowest levels of the marker. Experts suggest women preparing themselves for a healthy pregnancy should keep stress levels to a minimum. Relaxation techniques, counseling and even yoga and meditation are good choices.